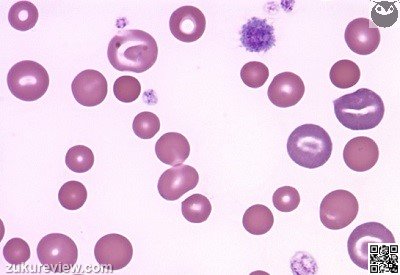
ac2sm 45

Monday, November 17
Question of the Day

On evaluation of red blood cell parameters what does anisocytosis mean, as demonstrated on the blood smear below?
On evaluation of red blood cell parameters what does anisocytosis mean, as demonstrated on the blood smear below?